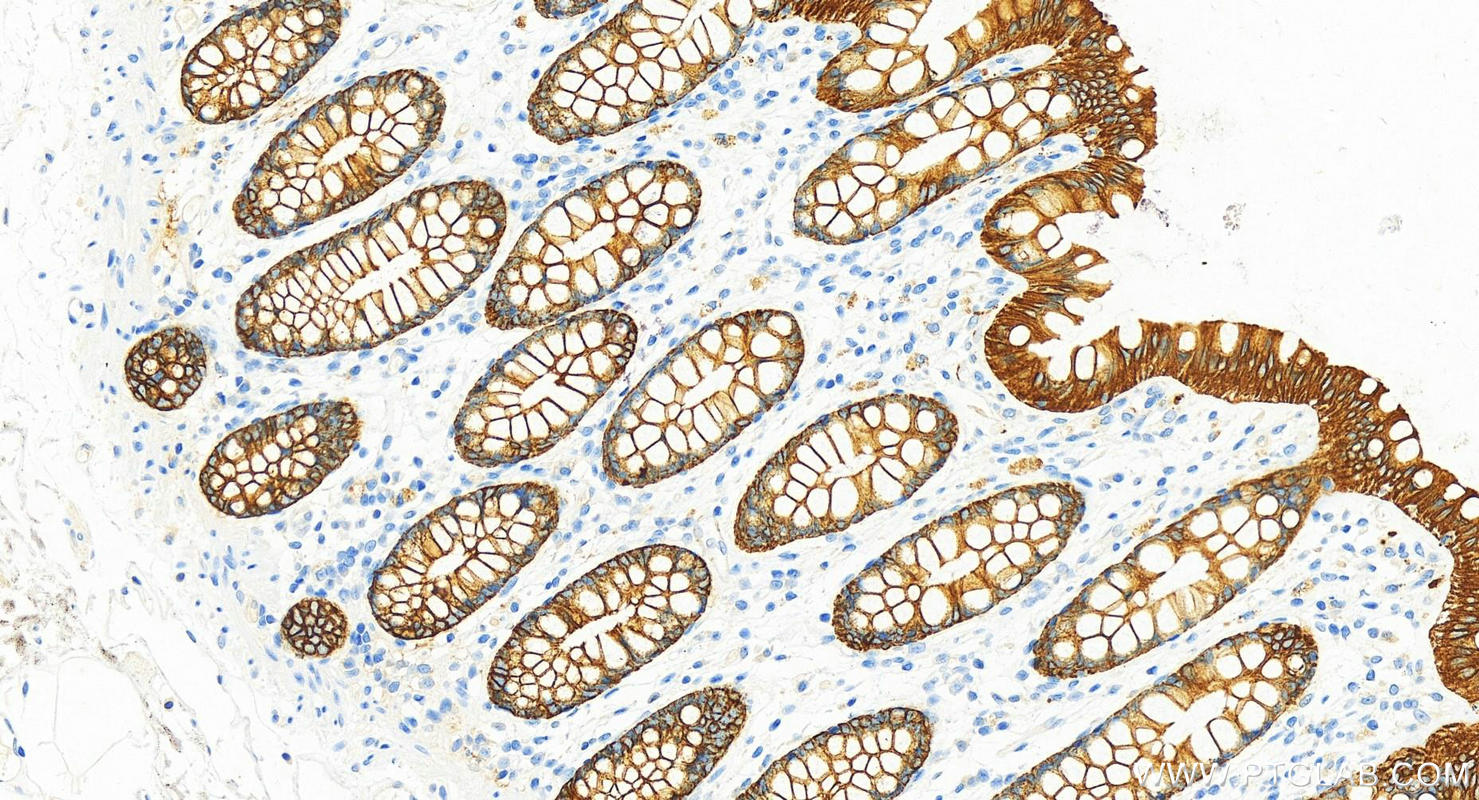
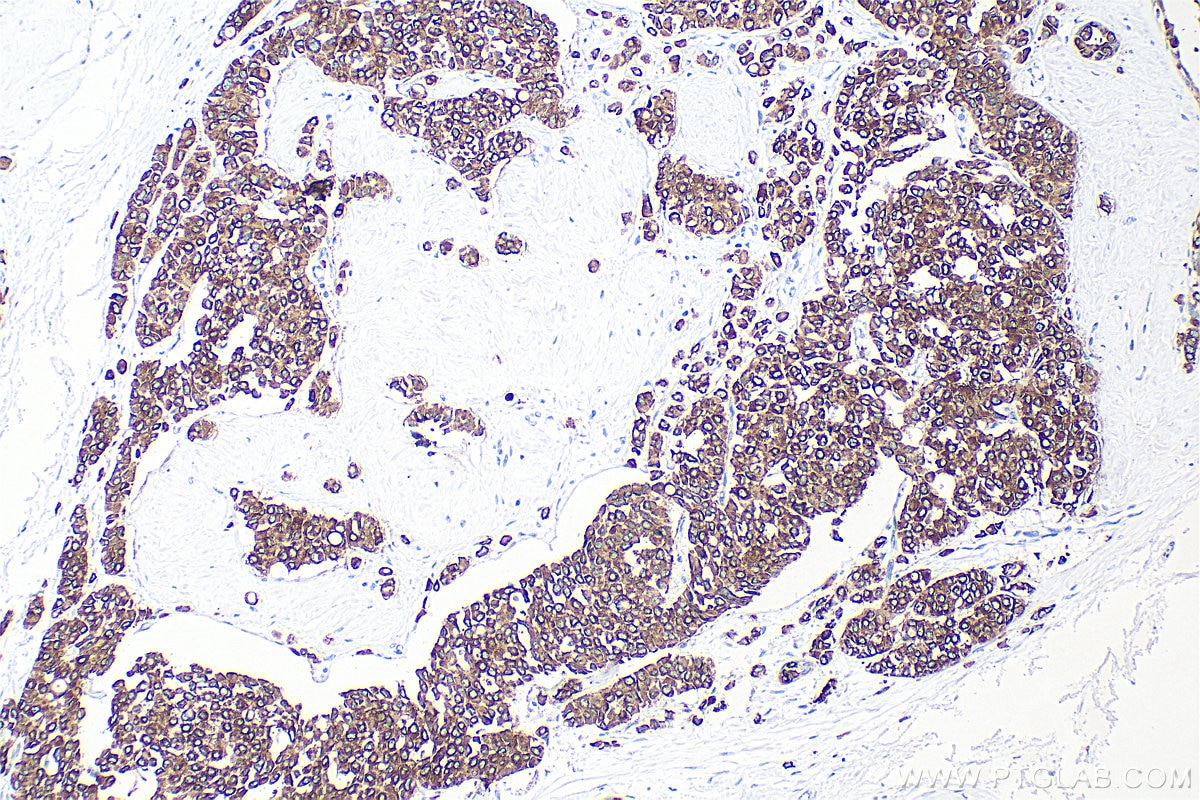
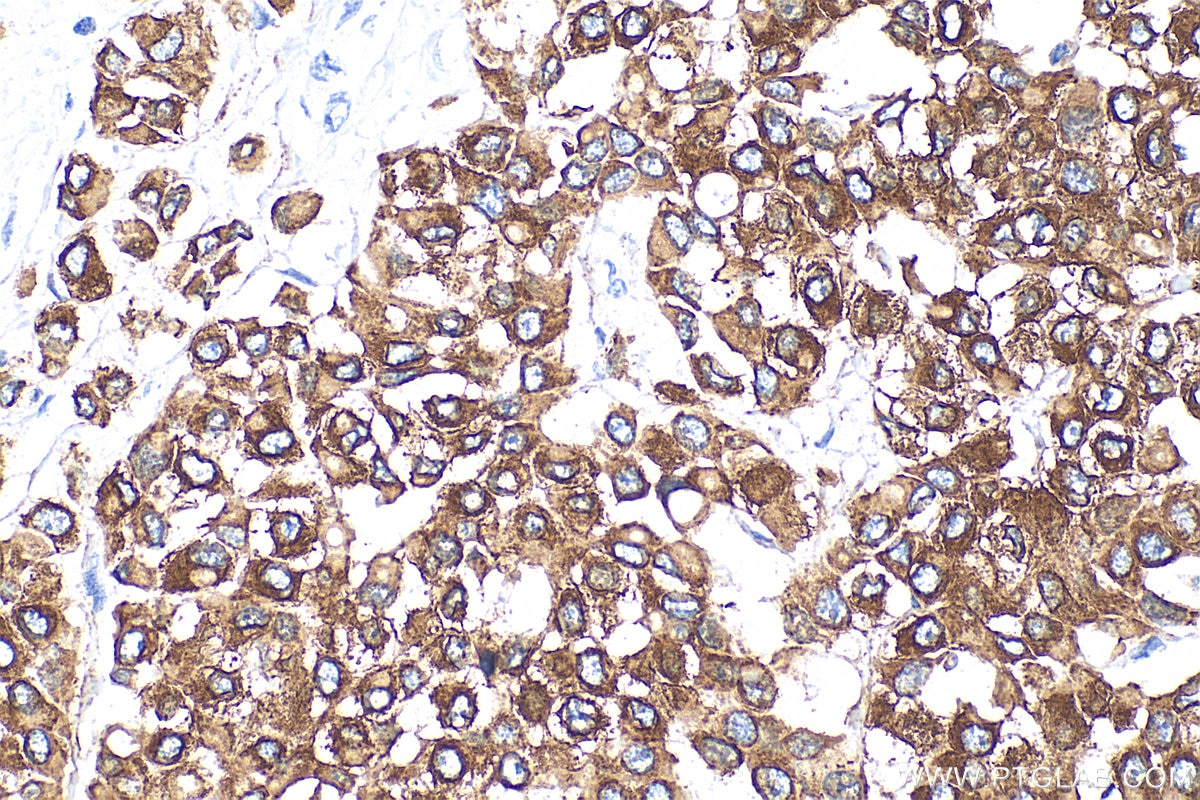

Tested Applications
| Positive WB detected in | HeLa cells, HaCaT cells, COLO 320 cells, A431 cells, A549 cells, MCF-7 cells, mouse skin tissue, rat skin tissue |
| Positive IP detected in | HeLa cells |
| Positive IHC detected in | human tonsillitis tissue, human appendicitis tissue, human bowen disease tissue, human breast cancer tissue, human colon tissue, human liver tissue, human renal cell carcinoma tissue Note: suggested antigen retrieval with TE buffer pH 9.0; (*) Alternatively, antigen retrieval may be performed with citrate buffer pH 6.0 |
| Positive IF-P detected in | human breast cancer tissue |
| Positive IF/ICC detected in | MCF-7 cells, HeLa cells, A431 cells |
| Positive FC (Intra) detected in | MCF-7 cells |
Recommended dilution
| Application | Dilution |
|---|---|
| Western Blot (WB) | WB : 1:5000-1:40000 |
| Immunoprecipitation (IP) | IP : 0.5-4.0 ug for 1.0-3.0 mg of total protein lysate |
| Immunohistochemistry (IHC) | IHC : 1:3000-1:12000 |
| Immunofluorescence (IF)-P | IF-P : 1:50-1:500 |
| Immunofluorescence (IF)/ICC | IF/ICC : 1:50-1:500 |
| Flow Cytometry (FC) (INTRA) | FC (INTRA) : 0.80 ug per 10^6 cells in a 100 µl suspension |
| It is recommended that this reagent should be titrated in each testing system to obtain optimal results. | |
| Sample-dependent, Check data in validation data gallery. | |
Published Applications
| KD/KO | See 2 publications below |
| WB | See 6 publications below |
| IHC | See 4 publications below |
| IF | See 10 publications below |
| IP | See 1 publications below |
Product Information
10384-1-AP targets Cytokeratin 8 in WB, IHC, IF/ICC, IF-P, FC (Intra), IP, ELISA applications and shows reactivity with human, mouse, rat samples.
| Tested Reactivity | human, mouse, rat |
| Cited Reactivity | human, mouse, rat, pig, canine, hamster, goat |
| Host / Isotype | Rabbit / IgG |
| Class | Polyclonal |
| Type | Antibody |
| Immunogen |
CatNo: Ag0488 Product name: Recombinant human KRT8 protein Source: e coli.-derived, PGEX-4T Tag: GST Domain: 1-483 aa of BC000654 Sequence: MSIRVTQKSYKVSTSGPRAFSSRSYTSGPGSRISSSSFSRVGSSNFRGGLGGGYGGASGMGGITAVTVNQSLLSPLVLEVDPNIQAVRTQEKEQIKTLNNKFASFIDKVRFLEQQNKMLETKWSLLQQQKTARSNMDNMFESYINNLRRQLETLGQEKLKLEAELGNMQGLVEDFKNKYEDEINKRTEMENEFVLIKKDVDEAYMNKVELESRLEGLTDEINFLRQLYEEEIRELQSQISDTSVVLSMDNSRSLDMDSIIAEVKAQYEDIANRSRAEAESMYQIKYEELQSLAGKHGDDLRRTKTEISEMNRNISRLQAEIEGLKGQRASLEAAIADAEQRGELAIKDANAKLSELEAALQRAKQDMARQLREYQELMNVKLALDIEIATYRKLLEGEESRLESGMQNMSIHTKTTSGYAGGLSSAYGGLTSPGLSYSLGSSFGSGAGSSSFSRTSSSRAVVVKKIETRDGKLVSESSDVLPK Predict reactive species |
| Full Name | keratin 8 |
| Calculated Molecular Weight | 54 kDa |
| Observed Molecular Weight | 52 kDa |
| GenBank Accession Number | BC000654 |
| Gene Symbol | Cytokeratin 8 |
| Gene ID (NCBI) | 3856 |
| RRID | AB_10638912 |
| Conjugate | Unconjugated |
| Form | Liquid |
| Purification Method | Antigen affinity purification |
| UNIPROT ID | P05787 |
| Storage Buffer | PBS with 0.02% sodium azide and 50% glycerol, pH 7.3. |
| Storage Conditions | Store at -20°C. Stable for one year after shipment. Aliquoting is unnecessary for -20oC storage. 20ul sizes contain 0.1% BSA. |
Background Information
Cytokeratin 8 (CK8) is a protein that belongs to the cytokeratin family, which is a group of structural proteins found in the intracytoplasmic cytoskeleton of epithelial cells. CK8 forms intermediate filaments within the cytoplasm of simple epithelial cells, typically as a dimer with cytokeratin 18 (CK18). These filaments provide a stabilizing framework that helps determine cell shape and enables cells to cope with mechanical stress. CK8/CK18 filaments also serve as a mesh of "paths" for signaling molecules, metabolites, and pathogens to travel within the cell in an organized manner. CK8 is expressed in various epithelial tissues and is particularly associated with glandular and simple epithelia. Its expression is also a significant marker in several types of cancer, including lung and esophageal cancer, where it can indicate tumor progression and poor prognosis.
Protocols
| Product Specific Protocols | |
|---|---|
| FC protocol for Cytokeratin 8 antibody 10384-1-AP | Download protocol |
| IF protocol for Cytokeratin 8 antibody 10384-1-AP | Download protocol |
| IHC protocol for Cytokeratin 8 antibody 10384-1-AP | Download protocol |
| IP protocol for Cytokeratin 8 antibody 10384-1-AP | Download protocol |
| WB protocol for Cytokeratin 8 antibody 10384-1-AP | Download protocol |
| Standard Protocols | |
|---|---|
| Click here to view our Standard Protocols |
Publications
| Species | Application | Title |
|---|---|---|
Dev Cell An integrated approach identifies the molecular underpinnings of murine anterior visceral endoderm migration | ||
Cell Mol Life Sci Crip2 affects vascular development by fine-tuning endothelial cell aggregation and proliferation | ||
J Cell Sci SNAP29 mediates the assembly of histidine-induced CTP synthase filaments in proximity to the cytokeratin network
| ||
Front Cell Dev Biol ESRRB Facilitates the Conversion of Trophoblast-Like Stem Cells From Induced Pluripotent Stem Cells by Directly Regulating CDX2. | ||
J Cell Sci SNAP29 mediates the assembly of histidine-induced CTP synthase filaments in proximity to the cytokeratin network.
| ||
Anat Rec (Hoboken) Comparative study of the external auditory canal in humans and large mammals. |